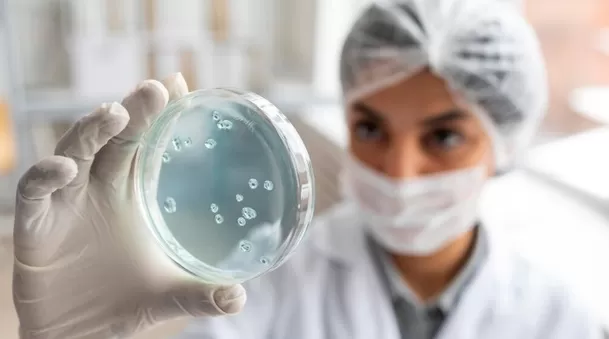

¿En cuánto tiempo se contamina un alimento luego de caer al piso?
Un experimento revela la cantidad de tiempo, el tipo de alimento y la superficie como factores determinantes para que resulte en contaminación el contacto con el suelo

Si alguna se te ha caído un alimento u objeto al piso, probablemente hayas creído que cuanto más rápido lo recojas, menos contaminado va a estar, ya que el tiempo de exposición a microorganismos es mínimo. Pero, ¿qué dice la ciencia frente a esta hipótesis?
No importa el tiempo cuando un alimento al piso
Una investigación realizada por la Universidad de Rutgers en Estados Unidos dio como resultado que la contaminación es inminente. Desde el primer momento en el que un alimento cae al piso, se llena de bacterias.
Donald Schaffner, profesor y especialista en extensión en ciencias de la alimentación, descubrió que la humedad, el tipo de superficie y el tiempo de contacto contribuyen a la contaminación cruzada, e incluso la transferencia puede darse en menos de un segundo.

El experimento que responde al mito
Para sustentar este hecho, se utilizó un pan con mantequilla y una sandía como alimentos, y los expusieron a un patógeno inofensivo en bajas cantidades, pero peligroso en altas concentraciones: Enterobacter aerogenes, un pariente no patógeno de la Salmonella presente de forma natural en el sistema digestivo humano.
Los resultados en ambos tipos de alimentos tuvieron una gran diferencia en cuanto al tiempo de exposición en el piso, sin embargo, la contaminación era inevitable.
El caso más destacable fue el de sandía, de la cual se descubrió que al estar menos de un segundo en el piso, ya tenía 91% de bacterias en su superficie y cinco segundos, el porcentaje ascendía a 97%.
Por otro lado, en el caso del pan con mantequilla, los científicos encontraron que se llenaba de bacterias en el 94% de su superficie con tan solo 30 segundos de exposición. Es decir, a mayor tiempo en el suelo, más colonización de gérmenes.
Cuánto más húmedo el alimento, mayor cantidad bacterias
Además de usar un pan de mantequilla y un pedazo de sandía, también se experimentó con unas gomitas de azúcar, un alimento menos húmedo, una característica que impidió una mayor colonización de bacterias.
“La transferencia de bacterias de las superficies a los alimentos parece verse más afectada por la humedad. Las bacterias no tienen patas; se mueven con la humedad, y cuanto más húmedo esté el alimento, mayor es el riesgo de transferencia”, afirmó Schaffner.
Asimismo, más allá de la humedad, está claro que el factor principal es el tiempo. El mayor tiempo de contacto del piso con los alimentos, suele resultar en la transferencia de más bacterias. Pero, así sea un segundo, siempre existe una exposición con microorganismos.

¿Qué superficies o suelos son menos contaminantes?
También es cierto que la superficie donde caiga un alimento u objeto es clave para cuantificar la transferencia de bacterias.
En la investigación mencionada se señala que la alfombra tiene una tasa muy baja en comparación con las baldosas y el acero inoxidable, mientras que la transferencia de la madera es más variable.








